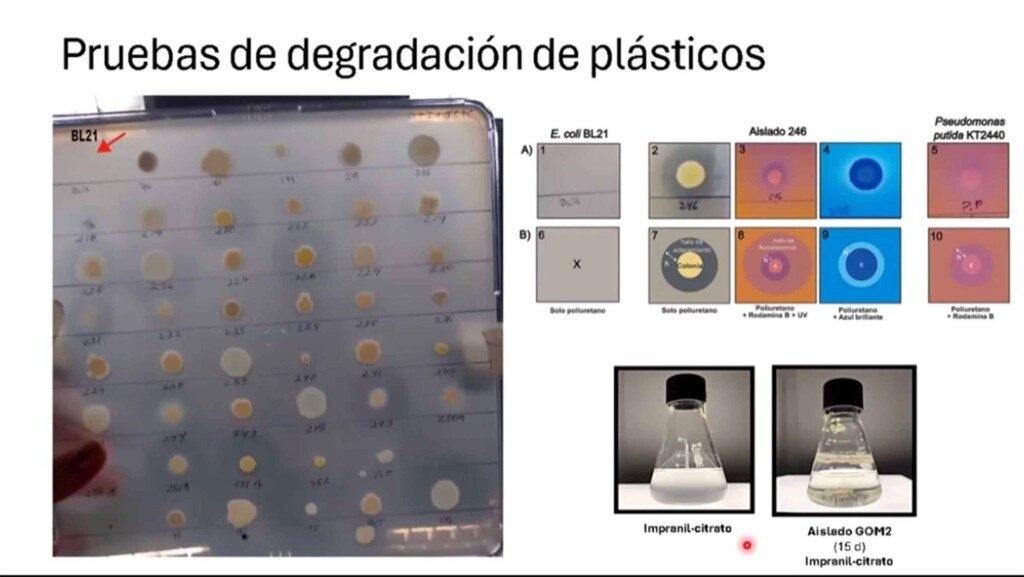

A nosotras nos interesaba especialmente una bacteria que no produjera tantas sustancias tóxicas: Liliana Pardo López y Nallely Magaña Montiel
Cada año se fabrican 18 millones de toneladas de poliuretano y solo 29.7 por ciento se recicla; es decir, 70 por ciento restante termina como un residuo en el ambiente.
Redacción
SemMéxico, Cd. de México, 29 de diciembre, 2025.- Una bacteria llamada Stutzerimonas frequens o GOM2, que en la naturaleza vive a mil metros de profundidad en el Golfo de México, fue identificada por científicas del Instituto de Biotecnología (IBt) de la UNAM como opción para degradar poliuretano.
Liliana Pardo López y Nallely Magaña Montiel detallaron en entrevista que forma parte de una colección de 300 cepas del laboratorio de Biotecnología Marina de dicha entidad académica recolectadas en diferentes campañas oceanográficas, de 2015 a la fecha.
Las expertas recordaron que desde que se inventaron los plásticos, en la segunda mitad del siglo pasado hasta la actualidad, se calcula que se han generado más de ocho mil 300 millones de toneladas de residuos, de los cuales se recicla aproximadamente nueve por ciento; 12 por ciento se incinera; y 79 por ciento se acumula en tierra, océanos y otras fuentes de agua.
Los principales plásticos producidos son polietileno, polipropileno, cloro de polivinilo y poliuretano, este último ha sido encontrado en zonas más lejanas como glaciares de las montañas, en lo más profundo del océano y en cuerpos de agua, invadiendo la cadena alimentaria.


Ellas son, en ese orden: Liliana Pardo López y Nallely Magaña Montiel
Pardo López destacó que cada año se fabrican 18 millones de toneladas de poliuretano y solo 29.7 por ciento se recicla; es decir, 70 por ciento restante termina como un residuo en el ambiente.
La científica precisó que estudian estas bacterias porque en el Golfo de México hay una gran cantidad de hidrocarburos que emanan naturalmente del subsuelo o debido a la exploración y explotación petrolera, razón por la cual están acostumbradas a comerlos.
La jefa de dicho laboratorio refirió: De 300 bacterias, Nallely Magaña Montiel seleccionó las que mejor degradaban plásticos; la sorpresa consistió en que muchas lo hacían, 80 por ciento fue capaz de consumir un tipo de plástico y 20 por ciento logró consumir tres tipos diferentes de plásticos. De esa manera se escogió a las más capaces.
Encontrar la correcta
Stutzerimonas frequens, presentada recientemente por las investigadoras en un artículo publicado en el Marine Pollution Bulletin, es capaz de degradar en 15 días 30 por ciento del poliuretano, lo cual es de destacarse respecto a los cientos de años que tardarían de forma natural.
Magaña Montiel expuso: Sabemos que cuando los plásticos se separan en sus partes individuales en el ambiente o por otros microorganismos, dejan residuos tóxicos. Lo que nos interesaba era encontrar una que fuera mejor en esa tarea, pero que no produjera tantas sustancias tóxicas.
La experta recién incorporada al Laboratorio del IBt pormenorizó que estos compuestos son conocidos como recalcitrantes en el ambiente, pero también entre los residuos hay productos que podrían ser candidatos para fabricar bioplásticos, incluso compuestos que tienen actividad biológica antifúngica o antimicrobiana.
Por ello, las investigadoras, en colaboración con Denhi Schnabel, realizaron un ensayo que incluyó el uso de embriones de pez cebra para ver qué pasaba con ellos después de esos 15 días. Encontrando que se redujo 80 por ciento la tasa de mortalidad.
Luego de los resultados obtenidos, ahora el reto es identificar qué otra bacteria puede degradar los compuestos que permanecieron, de tal manera que algún día podamos ir al supermercado y comprar un sobre de este conjunto de microorganismos para eliminar los plásticos que producimos.
Adicionalmente, se inició un estudio de transcriptómica para saber qué genes se están expresando cuando está la bacteria actuando y qué ventaja nos da, todo ello con el objetivo de llegar a una ingeniería metabólica.
Pardo López añadió que los plásticos son complejos porque cada uno tiene múltiples compuestos además del propio polímero, como aditivos, colorantes o coadyuvantes que les confieren propiedades específicas. Entonces una sola bacteria no tiene toda la maquinaria para degradar. Por eso, en el ambiente lo que hacen es trabajar en conjunto; es decir, lo que una no se come, lo puede ingerir otra.



https://www.cepal.org
• Portada del sitio de la reunión: 
